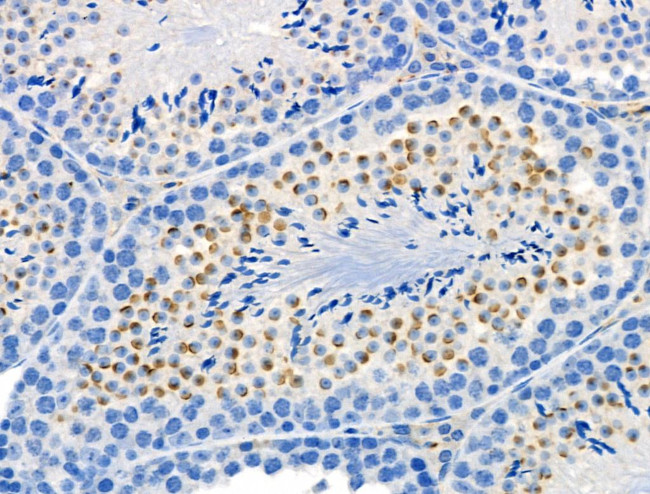
Phospho-Presenilin 1 (Ser353) Antibody in Immunohistochemistry (Paraffin) (IHC (P))

Search
Invitrogen
Phospho-Presenilin 1 (Ser353) Polyclonal Antibody
{{$productOrderCtrl.translations['antibody.pdp.commerceCard.promotion.promotions']}}
{{$productOrderCtrl.translations['antibody.pdp.commerceCard.promotion.viewpromo']}}
{{$productOrderCtrl.translations['antibody.pdp.commerceCard.promotion.promocode']}}: {{promo.promoCode}} {{promo.promoTitle}} {{promo.promoDescription}}. {{$productOrderCtrl.translations['antibody.pdp.commerceCard.promotion.learnmore']}}
图: 1 / 3
Phospho-Presenilin 1 (Ser353) Antibody (PA5-118711) in IHC (P)



Please note: We are reviewing Western blot images included in the antibody testing data in our catalog, including those provided by third parties. Unless expressly labeled or annotated as “raw-unedited”, Western blot images included in the antibody testing data in our catalog may have been edited, optimized or otherwise adjusted for presentation.
产品信息
PA5-118711
种属反应
宿主/亚型
分类
类型
抗原
偶联物
形式
浓度
规格
纯化类型
保存液
内含物
保存条件
运输条件
RRID
产品详细信息
Antibody detects endogenous levels of Presenilin 1 only when phosphorylated at Ser353.
靶标信息
Presenilin1 was initially identified a marker of susceptibility to early-onset Alzheimer's disease. In addition to PEN2, nicastrin and APH-1, Presenilin1 forms the -gamma-secretase protein complex, a membrane-bound aspartyl protease that can cleave certain proteins at peptide bonds buried within the hydrophobic environment of the lipid bilayer. This cleavage is responsible for a key step in signaling from several cell-surface receptors and is thought to be required for the generation of the neurotoxic amyloid peptides that are central to the pathogenesis of Alzheimer's disease. Like the tumor necrosis factor-alpha-converting enzyme (TACE) and the beta-site cleavage enzyme (BACE) protease families, -gamma-secretase will cleave the amyloid precursor protein (APP), but within the intramembrane region of APP, resulting in either the non-toxic p3 (from the alpha and -gamma cleavage site) or the toxic Abeta amyloid peptide (from the beta and -gamma cleavage site). It is thought that accumulation of the Abeta peptide is the precursor to Alzheimer's disease. Multiple isoforms of presenilin1 are known to exist.
仅用于科研。不用于诊断过程。未经明确授权不得转售。
篇参考文献 (0)
生物信息学
蛋白别名: Alzheimer Disease 3; Minilin; Presenilin-1; presenilin1; Protein S182; PS-1; S182 protein; Senilin 1
基因别名: AD3; Ad3h; PS-1; PS1; PSEN1; PSNL1; S182
UniProt ID: (Rat) P97887, (Mouse) P49769
Entrez Gene ID: (Rat) 29192, (Mouse) 19164